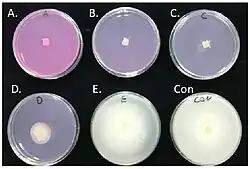

Virkon

Virkon est une marque de désinfectant virucide, bactéricide et fongicide à large spectre synonyme de monoperoxysulfate (HNaO5S)[1] qui est sont principal composant. Il associe un oxydant (le monopersulfate de potassium 22,5 %), des nettoyants l’acide sulfamique (5 %), l’acide malique (10 %) et un détergent le dodécylbenzènesulfonate de sodium. Virkon ® S est décrit comme un mélange stabilisé de composés péroxygénés, de tensioactifs, d'acides organiques et d'un système tampon inorganique.
Histoire
Virkon™ S a été lancé en 1986 par Antec International (Sudbury, Suffolk, Royaume-Uni) comme désinfectant agricole oxydant. Les publications académiques commencent à signaler Virkon en 1990 comme virucide (stérilisant de surface sur Listronotus bonariensis en Nouvelle-Zélande pour la prévention de la fièvre aphteuse[2], désinfection des poulaillers contre la bursite infectieuse[3], élimination du rhabdovirus des ophicéphalises (SHRV) dans l'eau avec dilution finale de 1:1000 pendant 15 min[4], inactivation du Infectious pancreatic necrosis (IPN) chez les poissons[5]. Vont suivre des évaluations scientifiques favorables[6] qui notent l'absence d'irritation ou d'effets toxiques sur les animaux[7], sur les infections à l'hôpital et la stérilisation des instruments chirurgicaux[8]. En 1997 il est testé comme un des meilleurs virucide contre le très résistant virus de l'hépatite B[9] et les échantillons cliniques à haut risque[10].
En 2001 il est massivement employé (54 millions de l par semaine) contre l’épidémie de fièvre aphteuse avec l'aide de DuPont Chemical qui en assure la distribution. DuPont Chemical acquiert Antec Intl en 2003[11].
En 2005 la double pulvérisation (2%) est démontré désinfectant contre Entérovirus A71[13], pour les pour adénovirus de types 5 et 6 (contact pendant 5 min)[14], et dans le domaine vétérinaire il inactive le virus A virus H5N1[15] de la grippe aviaire[16], il est homologué contre la peste porcine africaine[17], le virus de maladie de Newcastle (2021)[18]. En 2011 Virkon® Aquatic est un formulation destinée à l'aquaculture[19] domaine d'application où il est largement utilisé.
Présentation
Le produite est présenté sous forme de poudre soluble ou de granulés, en vrac ou en sachets. La solution est stable pendant 5 jours, la dégradation de la couleur rose indique la fin de la période de stabilité. Elle est utilisée en trempage, nébulisation ou pulvérisation.
Principale utilisations

Virkon S est utilisé en dilution comme désinfectant à large spectre (22 familles de virus, contre les bactéries, champignons, la teigne, les moisissures, levures et mycoplasmes), il est biodégradable à 90 % et utilisable en agriculture biologique[20]. Les principaux usages sont la désinfection des surfaces, des locaux, des cages, des équipements, du mobilier, des sols, des véhicules, dans le bains de bottes[21]. En milieu hospitalier il a été signalé contre SRAS-CoV-2[22], les oocystes de Cryptosporidium[23]. Les taux de dilutions ont pour ordre de grandeur 2 % pour les viroïdes, 1 % pour les bactéries, 0,25 à 0,5 % pour les champignons, 0,4 % pour les virus de la volaille[24].
Désinfection des instruments et outils de taille
On trouve Virkon S dans les classements de désinfectant pour les mains, les outils et l'équipement de taille contaminés. Chez le tobamovirus (virus du fruit rugueux brun de la tomate ToBRFV), le virus de la mosaïque verte du concombre (CGMMV)[25], le CEVd, ASBVd, PSTVd, etc. responsable de l'exocortis chez les agrumes sensibles greffés sur Poncirus trifoliata[26] avec une concentration de 2 %. Dans une étude sur le feu bactérien Virkon a été jugé moins efficace que l'eau de Javel pour tuer E. amylovora, mais il ne pas blanchi pas les vêtements, il est ininflammable[27].
Notes et références
- ↑ (en) PubChem, « Monoperoxysulfate », sur pubchem.ncbi.nlm.nih.gov (consulté le )
- ↑ S. L. Goldson, M. R. McNeill et J. R. Proffitt, « A method for comprehensive viral and bacterial disinfection of imported Curculionidae », New Zealand Entomologist, vol. 13, no 1, , p. 84–87 (ISSN 0077-9962, DOI 10.1080/00779962.1990.9722598, lire en ligne, consulté le )
- ↑ https://www.cabidigitallibrary.org/doi/full/10.5555/19882210115
- ↑ https://onlinelibrary.wiley.com/doi/pdf/10.1111/j.1439-0426.1990.tb00509.x
- ↑ https://www.ices.dk//sites/pub/CM%20Doccuments/1990/F/1990_F50.pdf
- ↑ https://www.cabidigitallibrary.org/doi/full/10.5555/19931378911
- ↑ (en) R. Gasparini, T. Pozzi, R. Magnelli et D. Fatighenti, « Evaluation of in vitro efficacy of the disinfectant Virkon », European Journal of Epidemiology, vol. 11, no 2, , p. 193–197 (ISSN 1573-7284, DOI 10.1007/BF01719487, lire en ligne, consulté le )
- ↑ https://www.cabidigitallibrary.org/doi/full/10.5555/19942050642
- ↑ (en) D. Scioli, T. Pizzella, L. Vollaro et S. Nardiello, « The action of VIRKON No Foam on the hepatitis B virus », European Journal of Epidemiology, vol. 13, no 8, , p. 879–883 (ISSN 1573-7284, DOI 10.1023/A:1007399926095, lire en ligne, consulté le )
- ↑ (en) Jennifer A. Moreton et H. Trevor, « Use of Virkon as a disinfectant for clinical samples carrying a high risk of infection in inductively coupled plasma mass spectrometry », Journal of Analytical Atomic Spectrometry, vol. 14, no 5, , p. 893–894 (DOI 10.1039/A809638D, lire en ligne, consulté le )
- ↑ (en) « DuPont Acquires Antec International », sur www.thepigsite.com (consulté le )
- ↑ (en) Haitham Saeed Rahman et Tae-Jin Choi, « The efficacy of Virkon-S for the control of saprolegniasis in common carp, Cyprinus carpio L », PeerJ, vol. 6, , e5706 (ISSN 2167-8359, DOI 10.7717/peerj.5706, lire en ligne, consulté le )
- ↑ Y F Chan et S Abu Bakar, « Virucidal activity of Virkon S on human enterovirus », The Medical journal of Malaysia, vol. 60, no 2, , p. 246–248 (ISSN 0300-5283, PMID 16114171, lire en ligne, consulté le )
- ↑ Lisa McCormick et Gargi Maheshwari, « Inactivation of adenovirus types 5 and 6 by Virkon® S », Antiviral Research, vol. 64, no 1, , p. 27–33 (ISSN 0166-3542, DOI 10.1016/j.antiviral.2004.04.008, lire en ligne, consulté le )
- ↑ (en) A. A. Avlicino, Bird Flu: What We Need to Know, Heritage House Publishing Co, (ISBN 978-1-894974-15-8, lire en ligne), p 64
- ↑ https://biosecurity.nl/wp-content/uploads/2015/09/Inactivation_effects_of_Virkon_S_on_AI_H9N2___H5N1.pdf
- ↑ (en) Guberti, V. , Khomenko, S. , Masiulis, M. , Kerba S, African swine fever in wild boar: Ecology and biosecurity, Food & Agriculture Org., (ISBN 978-92-5-136565-6, lire en ligne), p 92
- ↑ (en) Harimurti Nuradji, Anistisha Luthfiya Azmy, Ghea Aquatica et NLP Indi Dharmayanti, « The Effect of Common Detergents on The Causative Virus of Newcastle Disease », BIO Web of Conferences, vol. 33, , p. 06014 (ISSN 2117-4458, DOI 10.1051/bioconf/20213306014, lire en ligne, consulté le )
- ↑ (en) S. Christine Paetzold et Jeff Davidson, « Aquaculture fouling: Efficacy of potassium monopersulphonate triple salt based disinfectant (Virkon® Aquatic) against Ciona intestinalis », Biofouling, vol. 27, no 6, , p. 655–665 (ISSN 0892-7014, PMID 21722037, DOI 10.1080/08927014.2011.594503, lire en ligne, consulté le )
- ↑ « Sachet VIRKON S désinfectant en poudre bactéricide fongicide et virucide », sur www.hyprodis.fr (consulté le )
- ↑ (en) George V. Kurladze, Environmental Microbiology Research Trends, Nova Publishers, (ISBN 978-1-60021-939-9, lire en ligne)
- ↑ (en) J. Thylefors, S. Thuresson, M. Alsved et A. Widell, « Detection of SARS-CoV-2 RNA on surfaces in a COVID-19 hospital ward indicates airborne viral spread », Journal of Hospital Infection, vol. 124, , p. 121–122 (ISSN 0195-6701 et 1532-2939, PMID 35283226, PMCID PMC8912984, DOI 10.1016/j.jhin.2022.02.025, lire en ligne, consulté le )
- ↑ (en) Thomas J. Divers et Simon F. Peek, Rebhun's Diseases of Dairy Cattle, Elsevier Health Sciences, (ISBN 978-1-4160-3137-6, lire en ligne)
- ↑ (en) H. V. S. Chauhan, Poultry Diseases,Diagnosis And Treatment, New Age International, (ISBN 978-81-224-1023-5, lire en ligne)
- ↑ (en) Bidisha Chanda, Md Shamimuzzaman, Andrea Gilliard et Kai-Shu Ling, « Effectiveness of disinfectants against the spread of tobamoviruses: Tomato brown rugose fruit virus and Cucumber green mottle mosaic virus », Virology Journal, vol. 18, no 1, , p. 7 (ISSN 1743-422X, PMID 33407624, PMCID PMC7787650, DOI 10.1186/s12985-020-01479-8, lire en ligne, consulté le )
- ↑ https://static1.squarespace.com/static/623b5f3d4c76e5257401527d/t/635c29034b39565ec884aabb/1666984196529/Tool+sterilization+comprehensive+report-1.pdf#page=16.27
- ↑ (en) Mary B. Horner, Jayne Newland et Tyler McCourt, « Efficacy of sterilants to kill Erwinia amylovora », Journal of Plant Pathology, vol. 106, no 3, , p. 883–888 (ISSN 2239-7264, DOI 10.1007/s42161-023-01584-x, lire en ligne, consulté le )
- Portail de la chimie
- Portail de la biochimie
- Portail de la protection des cultures